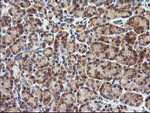
CTAG1B Antibody in Immunohistochemistry (Paraffin) (IHC (P))
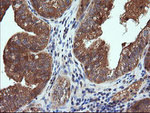
CTAG1B Antibody in Immunohistochemistry (Paraffin) (IHC (P))

Search
OriGene
CTAG1B Monoclonal Antibody (OTI5H4), TrueMAB™
{{$productOrderCtrl.translations['antibody.pdp.commerceCard.promotion.promotions']}}
{{$productOrderCtrl.translations['antibody.pdp.commerceCard.promotion.viewpromo']}}
{{$productOrderCtrl.translations['antibody.pdp.commerceCard.promotion.promocode']}}: {{promo.promoCode}} {{promo.promoTitle}} {{promo.promoDescription}}. {{$productOrderCtrl.translations['antibody.pdp.commerceCard.promotion.learnmore']}}
产品信息
TA505959
种属反应
宿主/亚型
分类
类型
克隆号
抗原
偶联物
形式
浓度
纯化类型
保存液
内含物
保存条件
运输条件
靶标信息
The protein encoded by CTAG1B is an antigen that is overexpressed in many cancers but that is also expressed in normal testis. This gene is found in a duplicated region of the X-chromosome and therefore has a neighboring gene of identical sequence.
仅用于科研。不用于诊断过程。未经明确授权不得转售。
篇参考文献 (0)
生物信息学
蛋白别名: Autoimmunogenic cancer/testis antigen NY-ESO-1; cancer antigen 3; Cancer/testis antigen 1; Cancer/testis antigen 6.1; CT6.1; L antigen family member 2; LAGE-2; New York esophageal squamous cell carcinoma 1
基因别名: CT6.1; CTAG; CTAG1; CTAG1A; CTAG1B; ESO1; LAGE-2; LAGE2; LAGE2A; LAGE2B; NY-ESO-1
UniProt ID: (Human) P78358
Entrez Gene ID: (Human) 1485